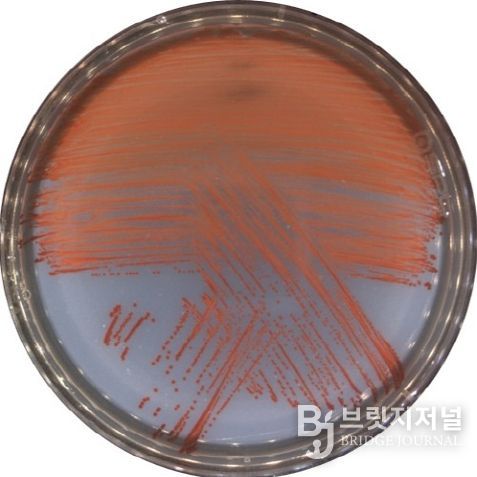
신종 비브리오 VRS2 균주를 배양한 사진(적색의 프로디지오신을 생성함)

브릿지저널 김경미 기자 | 기후에너지환경부 산하 국립호남권생물자원관은 해양 환경에서 분리한 신종 비브리오균이 강력한 천연 항균물질 ‘프로디지오신(prodigiosin)’을 생성하는 사실을 확인하고, 11월 24일 해당 기술을 특허 출원했다고 밝혔다.
프로디지오신은 일부 해양·토양 미생물에서 소량 생성되는 천연 적색 색소로, 항균, 항염증, 항암 활성을 갖는 유용한 생리활성 물질로 알려져 있다. 연구진이 확보한 신종 비브리오 VRS2(HNIBR-BC3459) 균주는 프로디지오신을 안정적으로 생성하는 특징을 보였으며, 특정 병원성 비브리오균에 대한 항균 활성을 나타내 친환경 생물제재로서의 활용 가능성이 확인됐다.
비브리오증은 양식 어류와 패류에서 반복적으로 발생하는 대표적인 세균성 질병으로, 국내 수산양식 산업의 생산성 저하와 경제적 피해를 초래해왔다. 연구진은 VRS2 균주로부터 추출한 색소가 주요 비브리오증 원인균인 비브리오 하베이, 비브리오 안귤라룸, 비브리오 알기놀리티쿠스, 비브리오 불니피쿠스, 비브리오 파라헤몰리티쿠스 뿐만 아니라 황색포도상구균, 표피포도상구균 등 일부 인체 병원균에 대해서도 항균 활성을 보였다고 밝혔다.
국립호남권생물자원관은 국내 섬과 연안 지역의 생물자원을 체계적으로 발굴하고 조사하여 생물주권의 조기 확립과 고부가가치 생물소재 창출을 함께 추진하고 있는 국가 연구기관이다.
송혜선 전임연구원은 “신종 비브리오균 VRS2가 생산하는 프로디지오신은 기존의 화학적 또는 항생제 기반 방제법의 한계를 보완할 수 있는 유망한 대안 물질”이라며, “이를 활용한 친환경 수산용 생물제제는 항생제 사용을 줄이면서 어류와 패류의 비브리오증 예방 및 관리 기술로 발전할 수 있다”라고 설명했다.
이번 연구는 양식 환경에서 발생하는 수산 질병 문제를 해결할 수 있는 새로운 접근법으로 평가되며, 향후 친환경 수산 항균 소재 개발 및 인체용 항균제 기초 소재로도 확장될 가능성이 기대된다.












